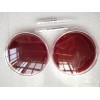
ATCC 20542土曲霉 ATCC菌種保藏中心

您好,歡迎來到給覽網(wǎng)! 官方微信 | 手機(jī)版 | 本站服務(wù) | 添加收藏 | 供應(yīng)歸檔
| 手機(jī)版 | 本站服務(wù) | 添加收藏 | 供應(yīng)歸檔
| 公司名稱 | 北京百歐博偉生物技術(shù)有限公司 | 公司認(rèn)證 | |
|---|---|---|---|
| 注冊年份 | 2013 | 公司類型 | 公司類型個體經(jīng)營 |
| 聯(lián)系人 | 李果 | 手機(jī) | 18610886853 |
| 電話 | 010-51293039 | 傳真 |
| 地址 | 北京豐臺北京豐臺區(qū)造甲街110號15幢 |
|---|

最新產(chǎn)品 | 最新資訊 | 商鋪新聞 | 刷新產(chǎn)品 | 免費(fèi) | 網(wǎng)站地圖 | 會員服務(wù) | 廣告服務(wù) | 公司介紹 | 聯(lián)系我們 | 用戶協(xié)議 | 意見反饋 | 儀器儀表采購群:92330156
?2010-2020 給覽網(wǎng) All Rights Reserved | 浙ICP備2024137035號 經(jīng)營許可證:浙B2-20140002  浙公網(wǎng)安備 33010502000340號
浙公網(wǎng)安備 33010502000340號
服務(wù)熱線:(0571) 81021182  傳真:(0571)81021183 客服熱線:0571-81187306
傳真:(0571)81021183 客服熱線:0571-81187306  展會/友鏈:
展會/友鏈: 郵箱:info#geilan.com
郵箱:info#geilan.com